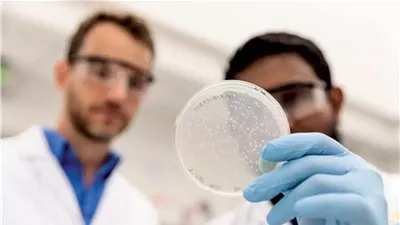
txt

مرض الزهايمر: 5 مهام منزلية قد تقلل من خطر الإصابة به

أدى الجمع بين الشيخوخة ونقص العلاجات لوقف المرض إلى تحفيز البحث عن تدابير وقائية، ويُعتبر نمط الحياة الآن أكثر عوامل الخطر القابلة للتعديل لهذا المرض، وتشير أبحاث جديدة إلى أن بعض الأعمال المنزلية قد تساعد في تقليل الخطر.
ووجدت دراسة جديدة أن حتى المهام البسيطة منخفضة التأثير مثل البستنة والطبخ وغسل الأطباق يمكن أن تقلل من خطر الإصابة بمرض الزهايمر إذا تم القيام بها بشكل متكرر.
وشملت الدراسة، التي نُشرت في مجلة Neurology، 716رجلاً وامرأة في السبعينيات والثمانينيات من العمر غير مصابين بالخرف.
وبالمقارنة مع الأشخاص الأكثر نشاطًا، كان لدى أولئك الذين لديهم أدنى مستويات النشاط البدني العام أكثر من ضعف خطر الإصابة بمرض الزهايمر، كما ارتبطت زيادة النشاط البدني أيضًا بمعدل أبطأ من الذاكرة والتدهور المعرفي المرتبط بالعمر.
وقال المؤلف الرئيسي الدكتور آرون إس. بوخمان، الأستاذ المشارك في العلوم العصبية في المركز الطبي بجامعة راش: "هذا يشير إلى أن الأشخاص في الثمانينيات من العمر الذين لا يستطيعون المشاركة في التمارين الرياضية الرسمية ما زالوا يستفيدون من كونهم أكثر نشاطًا".
وأضاف:لستَ مضطرًا للاشتراك في نادٍ رياضي محلي. ما عليك سوى صعود بضع خطوات إضافية، والوقوف، والبدء بغسل الأطباق، وستستفيد لأن ذلك تدريجي ويتراكم على مدار اليوم.
وجدت دراسة كندية أخرى أن كبار السن الذين يقضون وقتًا أطول في الأعمال المنزلية يتمتعون بأدمغة أكبر، وهو مؤشر موثوق على الصحة الإدراكية.
وأشار الباحثون إلى أن التركيز على فوائد الأعمال المنزلية قد يحفز كبار السن على زيادة نشاطهم البدني من خلال "توفير نشاط بدني أكثر واقعية وأقل خطورة".

تابعوا آخر أخبار بوابة الوفد الإلكترونية عبر نبض
تابعوا آخر أخبار بوابة الوفد الإلكترونية عبر نبض